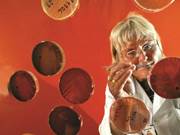

MRST Symposium 2021
Symposium took place online from 14th / 15th September 2021. The event had 169 registered participants and brought together a range of MRST users with many, varying interests with the aim of sharing experiences and inspiring each other in new scientific directions. The symposium consisted of 9 plenary talks from...